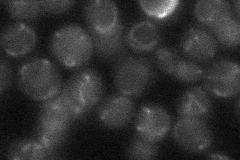
YPR067W

View description
Protein required for maturation of mitochondrial and cytosolic Fe/S proteins, localizes to the mitochondrial intermembrane space, overexpression of ISA2 suppresses grx5 mutations
Localization:
Intensity:
Fold change:
Significance:
-
C’ GFP library in SD

mitochondria32.07 -
N' NOP1pr-GFP in SD

mitochondria94.0327 -
N' TEF2pr-mCherry in SD

mitochondriaN/A -
N' NATIVEpr-GFP in SD
mitochondria22.3184 -
N' TEF2pr-VC and Cyto-VN in SD

#N/A0 -
C’ GFP library in SD+DTT

mitochondria31.840.99No -
C’ GFP library in SD+H2O2

mitochondria29.30.91No -
C’ GFP library in Starvation Media

mitochondria46.891.46Yes -
C’ GFP library on the background of Pup2-DaMP

mitochondria -
C’ GFP library on the background of CCT mutant

mitochondria33.24921.03633No
